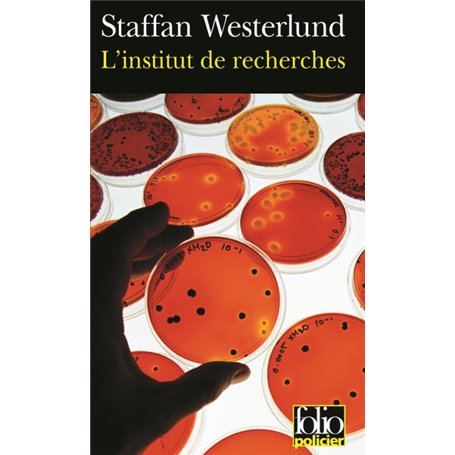
L'Institut de recherches

L'Institut de recherches
Editions FOLIO
Format PocheAuteur : Staffan Westerlund
Format PocheAuteur : Staffan Westerlund
10,70 €
TTC
Livraison sous 15 jours
Notes et avis clients
personne n'a encore posté d'avis
sur cet article

Livraison en Martinique tout compris

Retours et SAV simplifiés

Garantie Isleden
Description
Un corps retrouvé au large des côtes suédoises par des pêcheurs et qui a disparu le lendemain lorsque la police vient le chercher... Des maisons en principe vides appartenant à deux chercheurs du même institut, et qui brûlent simultanément avec leurs neuf occupants... Une journaliste retrouvée recroquevillée sur un îlot, morte d'un cancer, avec autour d'elle les cadavres de trois hommes armés... Drôle de Suède !Inga-Lisa Östergren, soeur de la dernière victime, ne compte pas en rester là. Secrète et déroutante, totalement atypique et d'un pragmatisme inflexible, la jeune femme va vite se retrouver au coeur d'un incroyable secret...
Caractéristiques
Caractéristiques
- Format
- Poche
- Auteur(s)
- Staffan Westerlund
- Traducteur(s)
- Philippe Bouquet
- Collection
- Folio policier
- Date de parution
- 20/01/2005
Livraison en Martinique avec Isleden
🇲🇶 Profitez d’un large choix de produits avec une livraison en Martinique sans frais de douane. Avec Isleden, vous commandez facilement en ligne et recevez vos achats en toute tranquillité.